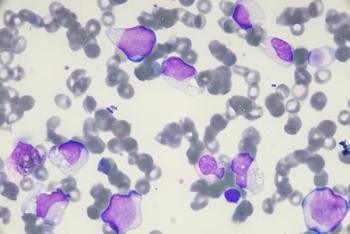
Blast cell in Acute myeloid leukemia from human blood cells (White blood cells cancer , Bone marrow aspirate)

Stem cell transplantation rates increased the longer patients remained on therapy for myelofibrosis.

Stem cell transplantation rates increased the longer patients remained on therapy for myelofibrosis.
The FDA approved treosulfan, in combination with fludarabine, for patients 1 year of age and older with acute myeloid leukemia (AML) or myelodysplastic syndrome (MDS).

Vusolimogene oderparepvec in combination with nivolumab is being assessed to treat individuals with unresectable or metastatic stage IIIb-IV cutaneous melanoma.

The caps on insulin and yearly out-of-pocket drug costs remain unaffected by this decision.

Engaging with the community, providing transparent information to patients, and using noncoercive methods of encouragement are strategies to reduce COVID-19 vaccine hesitancy.

A panel of experts discuss treatment of HR+, HER2– breast cancer with therapies such as ribociclib, alpelisib, everolimus, and elacestrant.

Regardless of confounding factors, the ratio of high-sensitivity C-reactive protein to high-density lipoprotein cholesterol predicts the all-cause long-term mortality.

An infusion and specialty clinical pharmacist is a valuable integrated member of the health care team as demonstrated by cost avoidance and high satisfaction reported by both veterans and specialty providers.

Many treatments are off-label, so pharmacists can educate clinicians and help patients with access.

The study shows benefits when Hecolin (HEV 239; Xiamen Innovax Biotech Co Ltd) is administered in 2 doses, rather than the typical 3-dose regimen.

Black and Native American patients were about 2 to 3 times more likely to die of cancer compared with White patients, and women younger than 50 years were affected more than male patients.

Pharmacists play a significant role in managing gout by educating patients about the disease and ensuring proper medication adherence to urate-lowering therapy.

A phase 2 trial investigates MRD detection and therapy advancements.

Pharmacists ensure responsible antibiotic use, combating resistance through tailored therapies.

At the start of 2025, 590 drug prices changed, with only 7 drugs seeing decreases in wholesale acquisition costs (WAC).

A series of patient cases demonstrates the potential harm that patients with chronic inflammatory demyelinating polyneuropathy (CIDP) may face when transitioning from intravenous immunoglobulin (IVIG) to FcRn therapy.

The study found that internalizing and externalizing factors, brain maturation, and decreasing volumes of brain regions were linked to eating disorders.

The international cohort study evaluated the safety, efficacy of BCMA-targeting agents ciltacabtagene autoleucel and idecabtagene vicleucel.

Multiple treatments have been approved by regulators for the treatment of hemophilia A and B, giving pharmacists options for their patients.

Raising awareness of the potentially fatal cardiovascular complications of epinephrine toxicity.

Investigators found that the polypill treatment improved cardiovascular disease and lowered health care costs.

KN026 is a humanized bispecific antibody that targets and binds to HER2 proteins on the surface of cancer cells.


In addition, pharmacists can screen for potential contraindications and drug-drug interactions.

Esketamine targets glutamate, the most abundant neurotransmitters in the brain.

Investigators assessed fixed-duration venetoclax plus acalabrutinib with or without obinutuzumab vs chemoimmunotherapy.

As H5N1 bird flu outbreaks impact all 50 states, concerns grow over its spread to humans.

Jennifer Clements, a clinical professor and the director of pharmacy education at the University of South Carolina, discusses the pharmacists role in diabetes care.

Recommendations help influence the rate of gastric emptying, improve compliance, and prevent interruption of weight loss for patients.